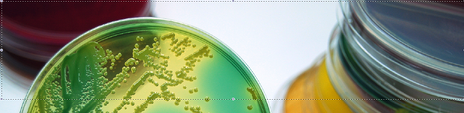
Texas A&M Research market

For laboratory suppliers reaching out to the Texas A&M University Marketplace you can take advantage of a free Premium upgrade with any Basic trade show registration package for today only.
Registration package must be purchased today (January 24, 2011). To see the flyer for the event go to Texas A&M University Trade Show For trade show and event promotion details, you may view our trade show information packet or contact Biotechnology Calendar, Inc. to understand the value of participating.
USE CODE TA&MSPB2 to take advantage of this special pricing. Available for phone orders only.

